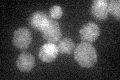
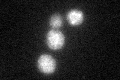
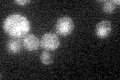

View description
Plasma membrane channel, member of major intrinsic protein (MIP) family; involved in efflux of glycerol and in uptake of acetic acid and the trivalent metalloids arsenite and antimonite; phosphorylated by Hog1p MAPK under acetate stress
Localization:
Intensity:
Fold change:
Significance:
-
C’ GFP library in SD
cell periphery28 -
N' NOP1pr-GFP in SD

cell periphery,punctate,vacuole55.1469 -
N' TEF2pr-mCherry in SD

cell periphery,vacuole79.9687 -
N' NATIVEpr-GFP in SD

below threshold22.4898 -
N' TEF2pr-VC and Cyto-VN in SD

cell periphery,punctate32.9353 -
C’ GFP library in SD+DTT
cell periphery25.770.92No -
C’ GFP library in SD+H2O2

cell periphery22.350.79No -
C’ GFP library in Starvation Media
cell periphery27.990.99No -
C’ GFP library on the background of Pup2-DaMP

cell periphery -
C’ GFP library on the background of CCT mutant

cell periphery22.59690.806934No
